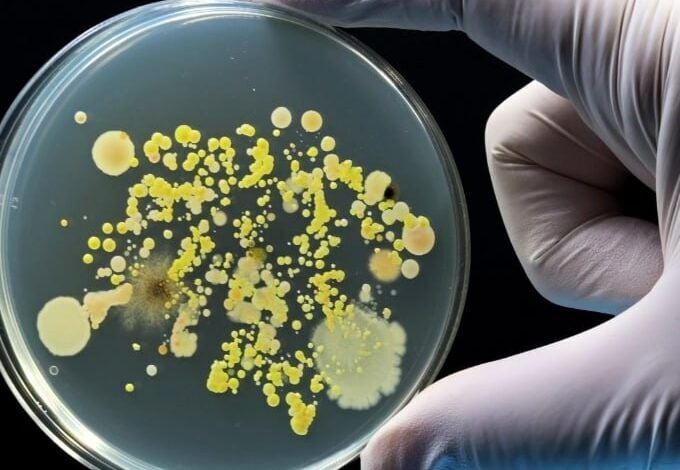

Hospitals See Alarming 460% Spike in NDM-CRE “Superbug” Infections
Hospitals See Alarming 460% Spike in NDM-CRE “Superbug” Infections
—————————–
Hospitals worldwide face a growing crisis as infections caused by NDM-CRE (NDM-producing carbapenem-resistant Enterobacterales)—bacteria resistant to most powerful antibiotics—have surged, according to a new study referenced on Earth.com.
The analysis, published in the Annals of Internal Medicine, reveals that NDM-CRE cases jumped over 460 percent between 2019 and 2023. This bacteria is particularly dangerous because it produces the New Delhi metallo-beta-lactamase (NDM) enzyme, which neutralizes almost all beta-lactam antibiotics.
The infections, which include pneumonia and bloodstream infections, carry high mortality risks, estimated between 26% and 44%. Experts emphasize that to combat the spread, hospitals urgently need faster diagnostic tools to identify the resistance mechanism and must strictly enforce basic infection control measures like hand hygiene and patient isolation.




